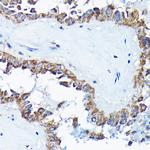
ETFA Antibody in Immunohistochemistry (Paraffin) (IHC (P))

Search
Invitrogen
ETFA Polyclonal Antibody
{{$productOrderCtrl.translations['antibody.pdp.commerceCard.promotion.promotions']}}
{{$productOrderCtrl.translations['antibody.pdp.commerceCard.promotion.viewpromo']}}
{{$productOrderCtrl.translations['antibody.pdp.commerceCard.promotion.promocode']}}: {{promo.promoCode}} {{promo.promoTitle}} {{promo.promoDescription}}. {{$productOrderCtrl.translations['antibody.pdp.commerceCard.promotion.learnmore']}}
图: 1 / 8
ETFA Antibody (PA5-121123) in IHC (P)

Please note: We are reviewing Western blot images included in the antibody testing data in our catalog, including those provided by third parties. Unless expressly labeled or annotated as “raw-unedited”, Western blot images included in the antibody testing data in our catalog may have been edited, optimized or otherwise adjusted for presentation.
产品信息
PA5-121123
种属反应
宿主/亚型
分类
类型
抗原
偶联物
形式
浓度
规格
纯化类型
保存液
内含物
保存条件
运输条件
RRID
产品详细信息
Positive test controls include: MCF7, A-549, SW620, HepG2, Mouse liver, Mouse kidney, Mouse heart, Rat liver. The target is usually found in the following locations: Mitochondrion matrix.
Immunogen sequence: MFRAAAPGQL RRAASLLRFQ STLVIAEHAN DSLAPITLNT ITAATRLGGE VSCLVAGTKC DKVAQDLCKV AGIAKVLVAQ HDVYKGLLPE ELTPLILATQ KQFNYTHICA GASAFGKNLL PRVAAKLEVA PISDIIAIKS PDTFVRTIYA GNALCTVKCD EKVKVFSVRG TSFDAAATSG GSASSEKASS TSPVEISEWL DQKLTKSDRP ELTGAKVVVS GGRGLKSGEN FKLLYDLADQ LHAAVGASRA AVDAGFVPND MQVGQTGKIV APELYIAVGI SGAIQHLAGM KDSKTIVAIN KDPEAPIFQV ADYGIVADLF KVVPEMTEIL KKK
靶标信息
ETFA participates in catalyzing the initial step of the mitochondrial fatty acid beta-oxidation. It shuttles electrons between primary flavoprotein dehydrogenases and the membrane-bound electron transfer flavoprotein ubiquinone oxidoreductase. Defects in electron-transfer-flavoprotein have been implicated in type II glutaricaciduria in which multiple acyl-CoA dehydrogenase deficiencies result in large excretion of glutaric, lactic, ethylmalonic, butyric, isobutyric, 2-methyl-butyric, and isovaleric acids. Two transcript variants encoding different isoforms have been found for this gene.
仅用于科研。不用于诊断过程。未经明确授权不得转售。
篇参考文献 (0)
生物信息学
蛋白别名: Alpha-ETF; Electron transfer flavoprotein subunit alpha, mitochondrial; electron transferring flavoprotein, alpha polypeptide
基因别名: 2010200I21Rik; D9Ertd394e; ETF; ETFA
UniProt ID: (Mouse) Q99LC5, (Rat) P13803
Entrez Gene ID: (Mouse) 110842, (Rat) 300726




